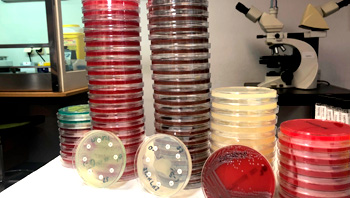

La Semana de la Ciencia y la Innovación de Madrid es un evento de divulgación científica y participación ciudadana organizado por la Fundación para el Conocimiento madri+d con el objetivo de involucrar activamente a los ciudadanos en la ciencia, la tecnología y la innovación y, de forma especial a los más jóvenes para fomentar las vocaciones científicas eliminando las barreras de género desde los primeros ciclos formativos.
BIOBANCOS: un compromiso con la ciencia
Lunes 5 de 11:30 a 14:30
Cirugía mínimamente invasiva. Cirugía del siglo XXI
Lunes 12 de 11:30 a 14:00
Martes 13 de 13:30 a 15:30
Diagnóstico microbiológico de las enfermedades infecciosas
Jueves 15 de 11:00 a 13:00
Inmersión en el hospital del futuro: Unidades de Innovación, impresión 3D y realidad virtual.
Jueves 8 de 9:00 a 11:00
Presente y futuro en enfermería, fisioterapia etc.: nuevos roles al servicio de todos
Martes 6 de 12:00 a 14:30
Lunes 12 de 9:00 a 11:30
Prevención consumo alcohol y drogas en la adolescencia temprana
Lunes 5 de 12:00 a 14:00
Simulación clínica Hospital de La Princesa: abróchense los cinturones
Jueves 8 de 11:00 a 13:00
Viernes 16 de 11:00 a 13:00
Taller práctico. Nueva tecnología en el tratamiento
de enfermedades arteriales y venosas
Lunes 5 de 9:30 a 11:30
Tatuajes, piercings y enfermedades de transmisión sexual. Mitos y realidades
Miércoles 7 de 11:00 a 13:30
Miércoles 14 de 11:00 a 13:30
¿Cómo es la vida de un medicamento? Etapas del desarrollo clínico
Miércoles 14 de 10:30 a 12:30
Jueves 15 de 11:30 a 13:30
¿Investigación biomédica translacional? De la investigación básica a la aplicación clínica
Miércoles 7 de 10:00 a 12:00
Jueves 15 de 12:00 a 14:00